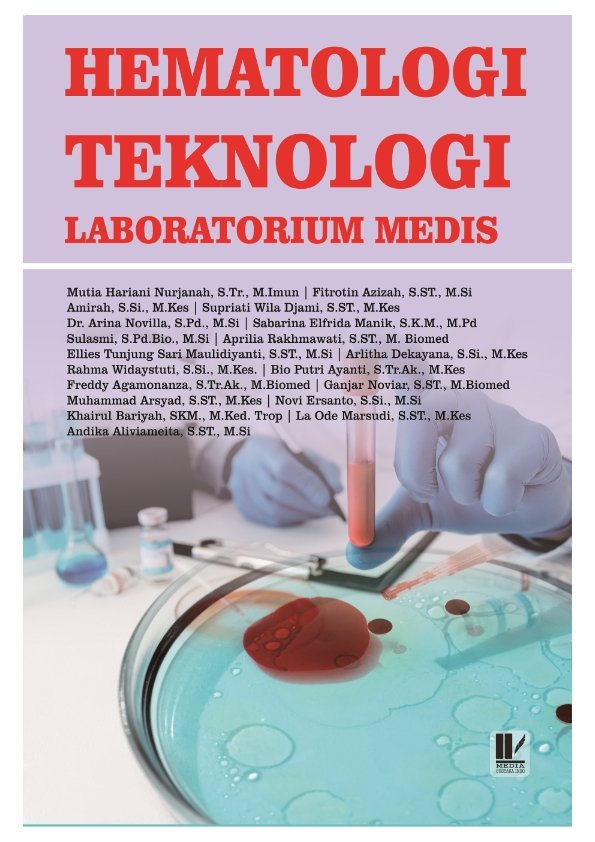
Hematologi Teknologi Laboratorium Medis

Data Science
Buku data science ini merupakan karya Dosen Prodi TI yaitu Muhammad Faqih Dzulqarnain dkk yang terbit pertama kali tahun 2024 yang diterbitkan oleh Penamuda Media.
Buku ini berisi tentang bagaimana data dan analisisnya mampu mengubah cara kita memahami dunia. Dari konsep dasar hingga aplikasi praktisnya.
Dengan penekanan pada teknik analisis data, visualisasi yang kuat, dan pemahaman mendalam tentang algoritma machine learning.
Buku ini tidak hanya memperkenalkan konsep-konsep kunci, tetapi juga memberikan wawasan yang berharga tentang bagaimana data dapat diubah menjadi wawasan berharga.